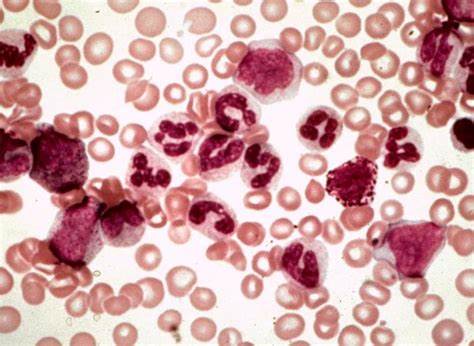
Лейкоз хронический диета Хронический лейкоз: симптомы, методы диагностики и терапия Хронический лейкоз: симптомы, методы диагностики и терапия Лейкоз хронический диета

Лейкоз хронический диета
Картинка 2: Лечебный стол 5 при панкреатите - 81 фото
Картинка 3: Хронические миелопролиферативные заболевания. Хронический миелогенный
Картинка 4: Острые лейкозы - презентация онлайн
Картинка 5: Хронический миело- и лимфолейкоз - причины, симптомы и виды - YouTube
Картинка 6: Что можно есть если камни в желчном пузыре
Картинка 7: Хронический лимфоцитарный лейкоз фото
Картинка 8: Ешь и худей голубцы - фото презентация
Картинка 9: Хронический лейкоз - причины и симптомы хронического лейкоза, лечение
Картинка 10: Какая диета при лейкозе поможет ускорить выздоровление?
Картинка 11: Острые лейкозы - презентация онлайн
Картинка 12: Фотография цитологического препарата биология (С множеством фото
Картинка 13: Диета При Дырявом Кишечнике - 49 фото
Картинка 14: Хронический миелоидный лейкоз: симптомы, что это такое, прогноз
Картинка 15: Рак крови
Картинка 16: Жан-филипп зермати | холецистит хронический диета
Картинка 17: Хронический лейкоз: чем отличается от острого, симптомы заболевания и
Картинка 18: Жан-филипп зермати | холецистит хронический диета
Картинка 19: Хронічний мієлоїдний лейкоз - Хемотека
Картинка 20: Хронический Панкреатит Диета Что Можно — Похудение Диета Правильное Питание
Картинка 21: Хронический миелобластный лейкоз у детей - презентация онлайн
Картинка 22: Жан-филипп зермати | холецистит хронический диета
Картинка 23: Диета Стол 5 Меню На Каждый — Похудение Диета Правильное Питание
Картинка 24: Не худеет живот | чай похудей cerera отзывы
Картинка 25: Пиявки ожирение
Картинка 26: Хронический лейкоз - презентация онлайн
Картинка 27: Острый мегакариобластный лейкоз
Картинка 28: Лейкоз: профилактика и питание при болезни
Картинка 29: Хронический Колит Лечение Препараты И Диета Кишечника — Похудение Диета
Картинка 30: Физические упражнения похудеть | диета лейкоз
Картинка 31: Рецепты греческой диеты | диета риты королевой отзывы
Картинка 32: Ангина фолликулярная
Картинка 33: Диета 9 - диета лейкоз
Картинка 34: Диета 9 - диета лейкоз
Картинка 35: Жан-филипп зермати | холецистит хронический диета
Картинка 36: Диета 9 - диета лейкоз
Картинка 37: Хронический лимфоцитарный лейкоз (ХЛЛ): симптомы, диагностика, лечение
Картинка 38: Холецистит хронический диета
Картинка 39: Хронический миелоидный лейкоз (ХМЛ)
Картинка 40: Хронический миелобластный лейкоз у детей - online presentation
Картинка 41: Лейкоз: причины, классификация, диагностика и лечение | ООО «Геномед»
Картинка 42: Хронический лимфолейкоз - презентация онлайн
Картинка 43: Холецистит хронический диета
Картинка 44: Хронический лимфоцитарный лейкоз (ХЛЛ): симптомы, диагностика, лечение
Картинка 45: Диета лейкоз - какую соблюдать диету при желчекаменной болезни
Картинка 46: Опухоли+системы+крови - Стр 9
Картинка 47: Онко Вики — Что такое острый лимфобластный лейкоз?
Картинка 48: Диета Поджелудочной Железы Примерное – Telegraph
Картинка 49: Диета лейкоз - какую соблюдать диету при желчекаменной болезни
Картинка 50: Диета лейкоз - какую соблюдать диету при желчекаменной болезни
Картинка 51: Хронический миелолейкоз: причины, стадии, методы диагностики | Медико
Картинка 52: Хронический миеломоноцитарный лейкоз
Картинка 53: Хронический лимфоцитарный лейкоз / лимфома из малых лимфоцитов
Картинка 54: «Прошла все стадии от отрицания до полного принятия»: как я лечу
Картинка 55: Лейкоз: признаки и симптомы, методы диагностики и лечения
Картинка 56: Хронический лейкоз: симптомы, методы диагностики и терапия
Картинка 57: Лейкоз
Картинка 58: Хронический лейкоз: симптомы, диагностика, лечение, стадии и
Картинка 59: Онко Вики — Какие бывают лейкозы? Что такое острый лейкоз?
Картинка 60: Хронический миелоидный лейкоз у детей [ХМЛ] – причины и лечение

Как с 65 похудеть до 55

Адапт диета форум апдиет

Кал на дисбактериоз диета

Что будет если похудеть на 20 кг

Диеты для похудения овсянка

Диета малышева как похудеть

Диета для желтухи у взрослых

Отзывы как похудеть при грудном вскармливании

Как похудеть с маслом оливковым

Вкусная диета 5 на неделю

Диета с кефиром и бананами

Похудеть редуксином отзывы

Диета камни в почки

Висцеральный жир убрать на животе

Как похудеть тринадцатилетней девочке

На сколько можно похудеть за 25 дней

Лечебные диеты по приказу 330

Диета на 2 месяца строгая
Не соблюдение диеты при панкреатите

Сколько нужно калорий в день чтобы похудеть женщине на 10 кг за месяц